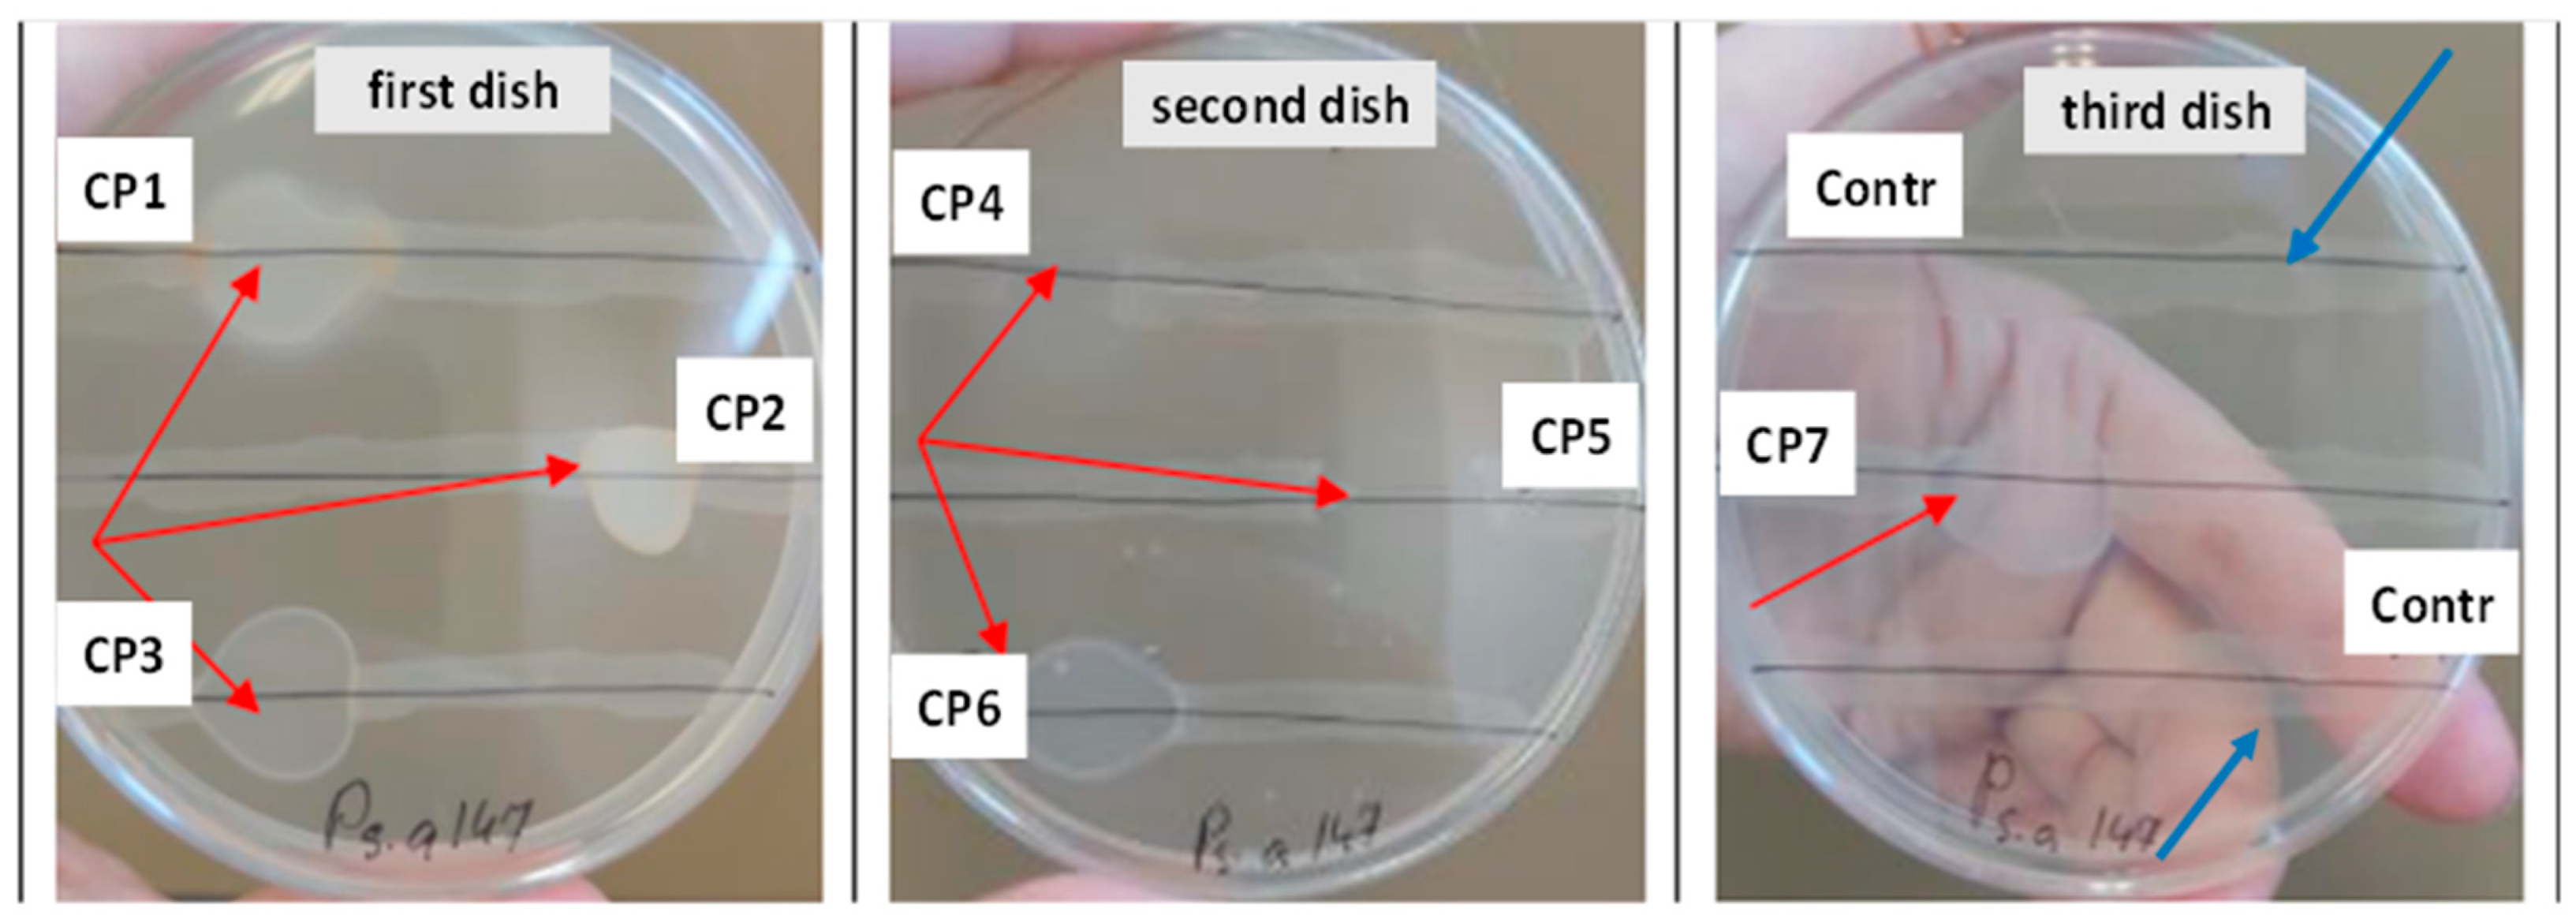

Thin Cationic Polymer Coatings against Foodborne Infections
Abstract
1. Introduction
2. Materials and Methods
2.1. Materials
2.2. Methods
3. Results and Discussion
4. Conclusions
Supplementary Materials
Author Contributions
Funding
Institutional Review Board Statement
Informed Consent Statement
Data Availability Statement
Conflicts of Interest
References
- Camargo, A.C.; Woodward, J.J.; Call, D.R.; Nero, L.A.; Santos, R.F.C.; Nascimento, J.d.S.; Geimba, M.P.; Hessel, C.T.; Tondo, E.C.; Karp, B.E.; et al. Listeria monocytogenes in food-processing facilities, food contamination, and human listeriosis: The Brazilian scenario. Foodborne Pathog. Dis. 2017, 14, 623–636. [Google Scholar] [CrossRef] [PubMed]
- Zhong, L.; Carere, J.; Lu, Z.; Lu, F.; Zhou, T. Patulin in apples and apple-based food products: The burdens and the mmitigation strategies. Toxins 2018, 10, 475. [Google Scholar] [CrossRef] [PubMed]
- Ayofemi Olalekan Adeyeye, S. Aflatoxigenic fungi and mycotoxins in food: A review. Crit. Rev. Food Sci. Nutr. 2020, 60, 709–721. [Google Scholar] [CrossRef] [PubMed]
- Begić, M.; Josić, D. Biofilm formation and extracellular microvesicles-The way of foodborne pathogens toward resistance. Electrophoresis 2020, 41, 1718–1739. [Google Scholar] [CrossRef] [PubMed]
- Resendiz-Moctezuma, C.; Rezac, S.D.; Miller, M.J.; Stasiewicz, M.J. Enabling cost-effective screening for antimicrobials against Listeria monocytogenes in ham. J. Food Prot. 2021, 84, 802–810. [Google Scholar] [CrossRef]
- Tang, S.; Stasiewicz, M.J.; Wiedmann, M.; Boor, K.J.; Bergholz, T.M. Efficacy of different antimicrobials on inhibition of Listeria monocytogenes growth in laboratory medium and on cold-smoked salmon. Int. J. Food. Microbiol. 2013, 165, 265–275. [Google Scholar] [CrossRef]
- Toushik, S.H.; Park, J.H.; Kim, K.; Ashrafudoulla, M.; Senakpon, I.U.M.; Mizan, M.F.R.; Roy, P.K.; Shim, W.B.; Kim, Y.M.; Park, S.H.; et al. Antibiofilm efficacy of Leuconostoc mesenteroides J.27-derived postbiotic and food-grade essential oils against Vibrio parahaemolyticus, Pseudomonas aeruginosa, and Escherichia coli alone and in combination, and their application as a green preservative in the seafood industry. Food Res. Int. 2022, 156, 111163. [Google Scholar] [CrossRef]
- Zezin, A.A. Synthesis of metal-polymer complexes and functional nanostructures in films and coatings of interpolyelectrolyte complexes. Polym. Sci. Ser. A 2019, 61, 754–764. [Google Scholar] [CrossRef]
- Kumar, S.B.; Arnipalli, S.R.; Ziouzenkova, O. Antibiotics in food chain: The consequences for antibiotic resistance. Antibiotics 2020, 9, 688. [Google Scholar] [CrossRef]
- Leyva Salas, M.; Mounier, J.; Valence, F.; Coton, M.; Thierry, A.; Coton, E. Antifungal microbial agents for food biopreservation-A review. Microorganisms 2017, 5, 37. [Google Scholar] [CrossRef]
- Jones, I.A.; Joshi, L.T. Biocide use in the antimicrobial era: A review. Molecules 2021, 26, 2276. [Google Scholar] [CrossRef] [PubMed]
- Moshynets, O.; Bardeau, J.F.; Tarasyuk, O.; Makhno, S.; Cherniavska, T.; Dzhuzha, O.; Potters, G.; Rogalsky, S. Antibiofilm activity of Polyamide 11 modified with thermally stable polymeric biocide polyhexamethylene guanidine 2-naphtalenesulfonate. Int. J. Mol. Sci. 2019, 20, 348. [Google Scholar] [CrossRef]
- Park, D.U.; Yang, K.W.; Kim, J.; Park, J.H.; Lee, S.Y.; Zoh, K.E.; Kwon, J.H.; Park, S.; Oh, H.B. Characteristics of the molecular weight of polyhexamethylene guanidine (PHMG) used as a household humidifier disinfectant. Molecules 2021, 26, 4490. [Google Scholar] [CrossRef]
- Walczak, K.; Thiele, J.; Geisler, D.; Boening, K.; Wieckiewicz, M. Effect of chemical disinfection on chitosan coated PMMA and PETG surfaces-An in vitro study. Polymers 2018, 10, 536. [Google Scholar] [CrossRef] [PubMed]
- Rashki, S.; Asgarpour, K.; Tarrahimofrad, H.; Hashemipour, M.; Ebrahimi, M.S.; Fathizadeh, H.; Khorshidi, A.; Khan, H.; Marzhoseyni, Z.; Salavati-Niasari, M.; et al. Chitosan-based nanoparticles against bacterial infections. Carbohydr. Polym. 2021, 251, 117108. [Google Scholar] [CrossRef]
- Guerra, G.P.; Rubin, M.A.; Mello, C.F. Modulation of learning and memory by natural polyamines. Pharmacol. Res. 2016, 112, 99–118. [Google Scholar] [CrossRef] [PubMed]
- Pillai, S.K.R.; Reghu, S.; Vikhe, Y.; Zheng, H.; Koh, C.H.; Chan-Park, M.B. Novel antimicrobial coating on silicone contact lens using glycidyl methacrylate and polyethyleneimine based polymers. Macromol. Rapid Commun. 2020, 41, e2000175. [Google Scholar] [CrossRef]
- Kopec, W.; Żak, A.; Jamróz, D.; Nakahata, R.; Yusa, S.I.; Gapsys, V.; Kepczynski, M. Polycation-anionic lipid membrane interactions. Langmuir 2020, 36, 12435–12450. [Google Scholar] [CrossRef]
- Wong, S.Y.; Li, Q.; Veselinovic, J.; Kim, B.S.; Klibanov, A.M.; Hammond, P.T. Bactericidal and virucidal ultrathin films assembled layer by layer from polycationic N-alkylated polyethylenimines and polyanions. Biomaterials 2010, 31, 4079–4087. [Google Scholar] [CrossRef]
- Samantaray, P.; Kumar, S.; Bose, S. ‘Polycation’ modified PVDF based antibacterial and antifouling membranes and ‘point-of-use supports’ for sustainable and effective water decontamination. J. Water Process. Eng. 2020, 38, 101536. [Google Scholar] [CrossRef]
- Klimov, D.I.; Zezina, E.A.; Lipik, V.C.; Abramchuk, C.C.; Yaroslavov, A.A.; Feldman, V.I.; Sybachin, A.V.; Spiridonov, V.V.; Zezin, A.A. Radiation-induced preparation of metal nanostructures in coatings of interpolyelectrolyte complexes. Radiat. Phys. Chem. 2019, 162, 23–30. [Google Scholar] [CrossRef]
- Cao, M.; Wang, J.; Wang, Y. Surface Patterns Induced by Cu2+ Ions on BPEI/PAA Layer-by-Layer Assembly. Langmuir 2007, 23, 3142–3149. [Google Scholar] [CrossRef] [PubMed]
- Ramos, J.; Forcada, J.; Hidalgo-Alvarez, R. Cationic Polymer Nanoparticles and Nanogels: From Synthesis to Biotechnological Applications. Chem. Rev. 2014, 114, 367–428. [Google Scholar] [CrossRef]
- Müller, M.; Keßler, B.; Fröhlich, J.; Poeschla, S.; Torger, B. Polyelectrolyte complex nanoparticles of poly(ethyleneimine) and poly(acrylic acid): Preparation and applications. Polymers 2011, 3, 3762–3778. [Google Scholar] [CrossRef]
- Pavlukhina, S.V.; Kaplan, J.B.; Xu, L.; Chang, W.; Yu, X.; Madhyastha, S.; Yakandawala, N.; Mentbayeva, A.; Khan, B.; Sukhishvili, S.A. Noneluting Enzymatic Antibiofilm Coatings. ACS Appl. Mater. Interfaces 2012, 4, 4708–4716. [Google Scholar] [CrossRef]
- Dai, J.; Bruening, M.L. Catalytic nanoparticles formed by reduction of metal ions in multilayered polyelectrolyte films. Nano Lett. 2002, 2, 497–501. [Google Scholar] [CrossRef]
- Pavlukhina, S.; Zhuk, I.; Mentbayeva, A.; Rautenberg, E.; Chang, W.; Yu, X.; van de Belt-gritter, B.; Busscher, H.J.; van der Mei, H.C.; Sukhishvili, S.A. Small-molecule-hosting nanocomposite films with multiple bacteria-triggered responses. NPG Asia Mater. 2014, 6, e121. [Google Scholar] [CrossRef]
- Timofeeva, L.; Kleshcheva, N. Antimicrobial polymers: Mechanism of action, factors of activity, and applications. Appl. Microbiol. Biotechnol. 2011, 89, 475–492. [Google Scholar] [CrossRef] [PubMed]
- Konai, M.M.; Bhattacharjee, B.; Ghosh, S.; Haldar, J. Recent progress in polymer research to tackle infections and antimicrobial resistance. Biomacromolecules 2018, 19, 1888–1917. [Google Scholar] [CrossRef]
- Misin, M.V.; Zezin, A.A.; Klimov, D.I.; Sybachin, A.V.; Yaroslavov, A.A. Biocidal polymer formulations and coatings. Polym. Sci. B 2021, 63, 459–469. [Google Scholar] [CrossRef]
- Jalageri, M.D.; Nagaraja, A.; Puttaiahgowda, Y.M. Piperazine based antimicrobial polymers: A review. RSC Adv. 2021, 11, 15213–15230. [Google Scholar] [CrossRef] [PubMed]
- Francolini, I.; Vuotto, C.; Piozzi, A.; Donelli, G. Antifouling and antimicrobial biomaterials: An overview. APMIS 2017, 125, 392–417. [Google Scholar] [CrossRef]
- Shahid, A.; Aslam, B.; Muzammil, S.; Aslam, N.; Shahid, M.; Almatroudi, A.; Allemailem, K.S.; Saqalein, M.; Nisar, M.A.; Rasool, M.H.; et al. The prospects of antimicrobial coated medical implants. J. Appl. Biomater. Funct. Mater. 2021, 19, 22808000211040304. [Google Scholar] [CrossRef]
- Bhattacharjee, B.; Jolly, L.; Mukherjee, R.; Haldar, J. An easy-to-use antimicrobial hydrogel effectively kills bacteria, fungi, and influenza virus. Biomater. Sci. 2022, 10, 2014–2028. [Google Scholar] [CrossRef]
- Mkrtchyan, K.V.; Pigareva, V.A.; Zezina, E.A.; Kuznetsova, O.A.; Semenova, A.A.; Yushina, Y.K.; Tolordava, E.R.; Grudistova, M.A.; Sybachin, A.V.; Klimov, D.I.; et al. Preparation of Biocidal Nanocomposites in X-ray Irradiated Interpolyelectolyte Complexes of Polyacrylic Acid and Polyethylenimine with Ag-Ions. Polymers 2022, 14, 4417. [Google Scholar] [CrossRef]
- Jiao, Y.; Niu, L.N.; Ma, S.; Li, J.; Tay, F.R.; Chen, J.H. Quaternary ammonium-based biomedical materials: State-of-the-art, toxicological aspects and antimicrobial resistance. Prog. Polym. Sci. 2017, 71, 53–90. [Google Scholar] [CrossRef]
- Dong, C.; Wang, Y.; Gonzalez, G.X.; Ma, Y.; Song, Y.; Wang, S.; Kang, S.M.; Compans, R.W.; Wang, B.Z. Intranasal vaccination with influenza HA/GO-PEI nanoparticles provides immune protection against homo- and heterologous strains. Proc. Natl. Acad. Sci. USA 2021, 118, e2024998118. [Google Scholar] [CrossRef] [PubMed]
- De Morais, S.C.; Bezerra, B.G.P.; Castro, B.B.; Balaban, R.D.C. Evaluation of polyelectrolytic complexes based on poly(epichlorohydrin-co-dimethylamine) and poly (4-styrene-sulfonic acid-co-maleic acid) in the delivery of polyphosphates for the control of CaCO3 scale in oil wells. J. Mol. Liq. 2021, 339, 116757. [Google Scholar] [CrossRef]
- Pigareva, V.; Stepanova, D.; Bolshakova, A.; Marina, V.; Osterman, I.; Sybachin, A. Hyperbranched Kaustamin as an antibacterial for surface treatment. Mendeleev Commun. 2022, 32, 561–563. [Google Scholar] [CrossRef]
- Razali, M.; Ahmad, Z.; Ahmad, M.; Ariffin, A. Treatment of pulp and paper mill wastewater with various molecular weight of polyDADMAC induced flocculation. Chem. Eng. J. 2011, 166, 529–535. [Google Scholar] [CrossRef]
- Francolini, I.; Galantini, L.; Rea, F.; Di Cosimo, C.; Di Cosimo, P. Polymeric Wet-Strength Agents in the Paper Industry: An Overview of Mechanisms and Current Challenges. Int. J. Mol. Sci. 2023, 24, 9268. [Google Scholar] [CrossRef]
- Verezhnikov, V.N.; Nikulin, S.S.; Poyarkova, T.N.; Misin, V.M. Separation of Styrene-Butadiene Rubbers from Latexes Using Dimethyldiallylammonium Chloride-SO2 Copolymer. Russ. J. Appl. Chem. 2001, 74, 1225–1229. [Google Scholar] [CrossRef]
- Pigareva, V.A.; Senchikhin, I.N.; Bolshakova, A.V.; Sybachin, A.V. Modification of Polydiallyldimethylammonium Chloride with Sodium Polystyrenesulfonate Dramatically Changes the Resistance of Polymer-Based Coatings towards Wash-Off from Both Hydrophilic and Hydrophobic Surfaces. Polymers 2022, 14, 1247. [Google Scholar] [CrossRef]
- Pearson, R.D.; Steigbigel, R.T.; Davis, H.T.; Chapman, S.W. Method for reliable determination of minimal lethal antibiotic concentrations. Antimicrob. Agents Chemother. 1980, 18, 699–708. [Google Scholar] [CrossRef] [PubMed]
- Jordan, K.; McAuliffe, O. Listeria monocytogenes in foods. Adv. Food Nutr. Res. 2018, 86, 181–213. [Google Scholar] [CrossRef] [PubMed]
- Bai, X.; Nakatsu, C.H.; Bhunia, A.K. Bacterial biofilms and their implications in pathogenesis and food safety. Foods 2021, 10, 2117. [Google Scholar] [CrossRef] [PubMed]
- Pigareva, V.A.; Marina, V.I.; Bolshakova, A.V.; Berkovich, A.K.; Kuznetsova, O.A.; Semenova, A.A.; Yushina, Y.K.; Bataeva, D.S.; Grudistova, M.A.; Sybachin, A.V. Biocidal Coatings against Gram-Positive Bacteria from Linear and Branched Polycations: The Decisive Role of the Diffusion Coefficients of Macromolecules. Coatings 2023, 13, 1076. [Google Scholar] [CrossRef]
- Hoque, J.; Akkapeddi, P.; Ghosh, C.; Uppu, D.S.; Haldar, J. A Biodegradable Polycationic Paint that Kills Bacteria in Vitro and in Vivo. ACS Appl. Mater. Interfaces 2016, 8, 29298–29309. [Google Scholar] [CrossRef] [PubMed]
- Rozhina, E.; Danilushkina, A.; Akhatova, F.; Fakhrullin, R.; Rozhin, A.; Batasheva, S. Biocompatibility of magnetic nanoparticles coating with polycations using A549 cells. J. Biotechnol. 2020, 325, 25–34. [Google Scholar] [CrossRef] [PubMed]
- Yin, B.; Liu, C. Combinatorial Research of Molecular Technologies and Surface Nanostructures Applied to the Development of Antifouling Coatings. J. Nanosci. Nanotechnol. 2019, 19, 3647–3653. [Google Scholar] [CrossRef]
- Teper, P.; Celny, A.; Kowalczuk, A.; Mendrek, B. Quaternized Poly(N,N′-dimethylaminoethyl methacrylate) Star Nanostructures in the Solution and on the Surface. Polymers 2023, 15, 1260. [Google Scholar] [CrossRef] [PubMed]
- Poerio, T. Non-covalent Binding for Polymer Surface Modification. In Encyclopedia of Membranes; Drioli, E., Giorno, L., Eds.; Springer: Berlin/Heidelberg, Germany, 2014. [Google Scholar] [CrossRef]
- Molotkovsky, R.J.; Galimzyanov, T.R.; Ermakov, Y.A. Heterogeneity in Lateral Distribution of Polycations at the Surface of Lipid Membrane: From the Experimental Data to the Theoretical Model. Materials 2021, 14, 6623. [Google Scholar] [CrossRef] [PubMed]
- Drobota, M.; Ursache, S.; Aflori, M. Surface Functionalities of Polymers for Biomaterial Applications. Polymers 2022, 14, 2307. [Google Scholar] [CrossRef]
- Pavan, C.; Santalucia, R.; Leinardi, R.; Fabbiani, M.; Yakoub, Y.; Uwambayinema, F.; Ugliengo, P.; Tomatis, M.; Martra, G.; Turci, F.; et al. Nearly free surface silanols are the critical molecular moieties that initiate the toxicity of silica particles. Proc. Natl. Acad. Sci. USA 2020, 117, 27836–27846. [Google Scholar] [CrossRef]
- Borisova, D.; Haladjova, E.; Kyulavska, M.; Petrov, P.; Pispas, S.; Stoitsova, S.; Paunova-Krasteva, T. Application of cationic polymer micelles for the dispersal of bacterial biofilms. Eng. Life Sci. 2018, 18, 943–948. [Google Scholar] [CrossRef]
- Mwangi, I.W.; Ngila, J.C.; Ndungu, P.; Msagati, T.A.M. Method Development for the Determination of Diallyldimethylammonium Chloride at Trace Levels by Epoxidation Process. Water Air Soil Pollut. 2013, 224, 1638. [Google Scholar] [CrossRef]
- Tiller, J.C.; Lee, S.B.; Lewis, K.; Klibanov, A.M. Polymer surfaces derivatized with poly(vinyl-N-hexylpyridinium) kill airborne and waterborne bacteria. Biotechnol. Bioeng. 2002, 79, 465–471. [Google Scholar] [CrossRef]
- Larson, A.M.; Hsu, B.B.; Rautaray, D.; Haldar, J.; Chen, J.; Klibanov, A.M. Hydrophobic polycationic coatings disinfect poliovirus and rotavirus solutions. Biotechnol. Bioeng. 2010, 108, 720–723. [Google Scholar] [CrossRef] [PubMed]

| Sample | Control | CP1 | CP2 | CP3 | CP4 | CP5 | CP6 | CP7 |
|---|---|---|---|---|---|---|---|---|
| CFU/mL | 2.6 × 107 | 2.0 × 104 | 2.0 × 104 | 6.0 × 104 | 7.0 × 104 | 4.8 × 105 | 4.0 × 104 | 2.0 × 104 |
| Sample | Control | CP1 | CP2 | CP3 | CP4 | CP5 | CP6 | CP7 | |
|---|---|---|---|---|---|---|---|---|---|
| CFU/mL | L. monocytogenes | 5.0 × 107 | 0 | 0 | 0 | 3.0 × 106 | 1.0 × 106 | 0 | 0 |
| P. aeruginosa | 8.0 × 107 | 0 | 0 | 3.3 × 104 | 1.7 × 103 | 2.0 × 104 | 2.3 × 105 | 0 |
| Sample | Control | CP1 | CP2 | CP3 | CP4 | CP5 | CP6 | CP7 |
|---|---|---|---|---|---|---|---|---|
| CFU/mL | 4.0 × 107 | 0 | 0 | 0 | 0 | 0 | 0 | 0 |
| Polymers | P. aeruginosa | L. monocytogenes | ||
|---|---|---|---|---|
| MIC, mg/mL | MBC, mg/mL | MIC, mg/mL | MBC, mg/mL | |
| CP1 | 10 | 20 | 5 | 5 |
| CP2 | 10 | 10 | 10 | 20 |
| CP3 | 20 | 20 | 5 | 10 |
| CP4 | 10 | 20 | 20 | 20 |
| CP5 | 10 | 10 | 20 | 20 |
| CP6 | >20 | >20 | 2.5 | 5 |
| CP7 | 5 | 5 | 1 | 1 |
Disclaimer/Publisher’s Note: The statements, opinions and data contained in all publications are solely those of the individual author(s) and contributor(s) and not of MDPI and/or the editor(s). MDPI and/or the editor(s) disclaim responsibility for any injury to people or property resulting from any ideas, methods, instructions or products referred to in the content. |
© 2023 by the authors. Licensee MDPI, Basel, Switzerland. This article is an open access article distributed under the terms and conditions of the Creative Commons Attribution (CC BY) license (https://creativecommons.org/licenses/by/4.0/).
Share and Cite
Yushina, Y.K.; Sybachin, A.V.; Kuznecova, O.A.; Semenova, A.A.; Tolordava, E.R.; Pigareva, V.A.; Bolshakova, A.V.; Misin, V.M.; Zezin, A.A.; Yaroslavov, A.A.; et al. Thin Cationic Polymer Coatings against Foodborne Infections. Coatings 2023, 13, 1389. https://doi.org/10.3390/coatings13081389
Yushina YK, Sybachin AV, Kuznecova OA, Semenova AA, Tolordava ER, Pigareva VA, Bolshakova AV, Misin VM, Zezin AA, Yaroslavov AA, et al. Thin Cationic Polymer Coatings against Foodborne Infections. Coatings. 2023; 13(8):1389. https://doi.org/10.3390/coatings13081389
Chicago/Turabian StyleYushina, Yuliya K., Andrey V. Sybachin, Oksana A. Kuznecova, Anastasia A. Semenova, Eteri R. Tolordava, Vladislava A. Pigareva, Anastasiya V. Bolshakova, Vyacheslav M. Misin, Alexey A. Zezin, Alexander A. Yaroslavov, and et al. 2023. "Thin Cationic Polymer Coatings against Foodborne Infections" Coatings 13, no. 8: 1389. https://doi.org/10.3390/coatings13081389
APA StyleYushina, Y. K., Sybachin, A. V., Kuznecova, O. A., Semenova, A. A., Tolordava, E. R., Pigareva, V. A., Bolshakova, A. V., Misin, V. M., Zezin, A. A., Yaroslavov, A. A., Bataeva, D. S., Kotenkova, E. A., Demkina, E. V., & Reshchikov, M. D. (2023). Thin Cationic Polymer Coatings against Foodborne Infections. Coatings, 13(8), 1389. https://doi.org/10.3390/coatings13081389

